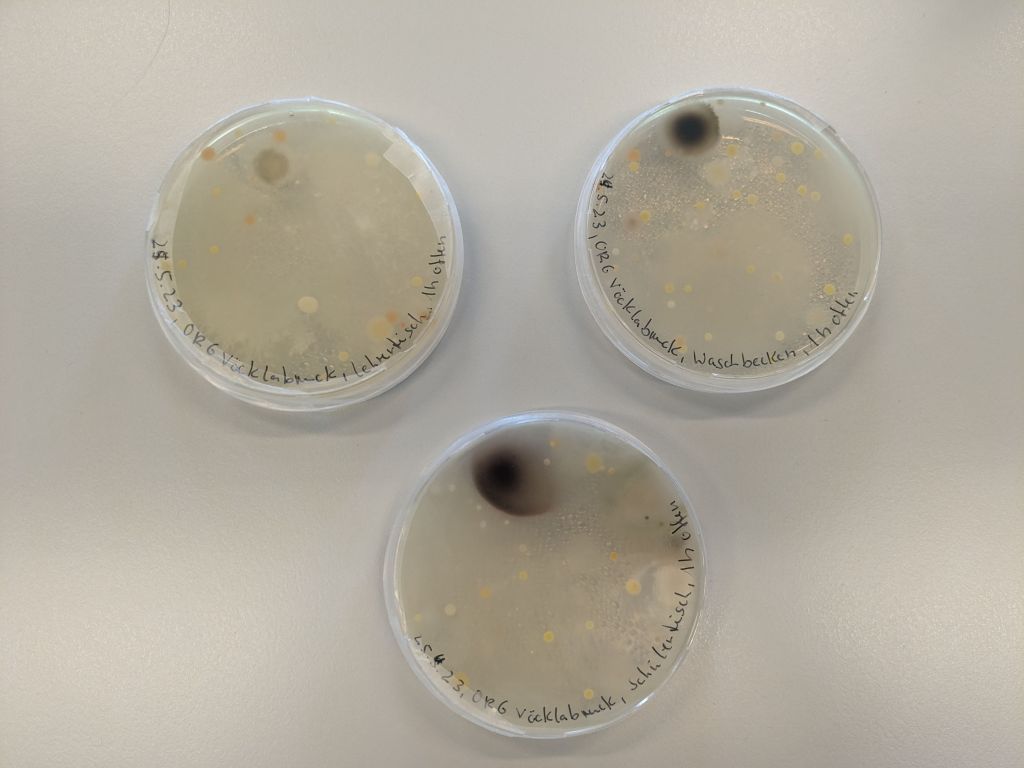

Am 6.6.23 waren Alexandra und Stefan wieder bei der 6c im ORG Vöcklabruck zu Gast. Mit den nur 11 Schüler/innen war es wieder ein gemütlicher Vormittag. Die Schüler/innen konnten eine ganze Menge zum Thema Bakterien beitragen, das hat uns sehr gefreut. Nur bei der Frage, zu welcher Organismengruppe der Mensch nun vom biologischen bzw. entwicklungsgeschichtlichen Standpunkt aus gehört, waren wir etwas verschiedener Meinung. Zu den Bakterien gehört er zumindest nicht 😉 , da waren sich alle einig.
Dann ging es daran die Agarplatten vom ersten Workshop zu begutachten. Das Parfüm war wohl schon etwas älteren Datums, denn es waren einige Bakterienkolonien auf den Platten gewachsen. Auf den sonstigen Agarplatten mit Flüssigkeiten, die hauptsächlich aus Alkohol bestehen, war nichts oder fast nichts zu sehen. Auf den mit Leitungswasser beimpften Agarplatten waren einige Bakterienkolonien gewachsen und auch ein paar Schimmelpilze. Bakterien dürfen im Leitungswasser sein, nur krankheitserregende Keime sollten da nicht vorkommen. Dann ging es daran die mitgebrachten Wasserproben zu filtrieren und auf Agarplatten mit unterschiedlicher Nährstoffzusammensetzung auszustreichen. Das ging dank der Übung aus dem ersten Workshop nun sehr gut, drei Schüler hatten sogar zwei Wasserproben mitgebracht. Eine Probe stammte ganz frisch aus einer Pfütze (ja, auch das ist ein Süßwasserlebensraum) von einem Parkplatz und wir haben sogar unser erstes und einziges Foto bekommen 🙂 Danke an Jamil 🙂 Die Wasserprobe von Denis kommt aus einem Brunnen in Rumänien, da sind wir besonders gespannt, ob wir darin unsere gesuchten Aquirufa Bakterien finden. Uns hat es auf alle Fälle Spaß gemacht, wir halten die Klasse auf dem Laufenden und kommen im Herbst wieder.